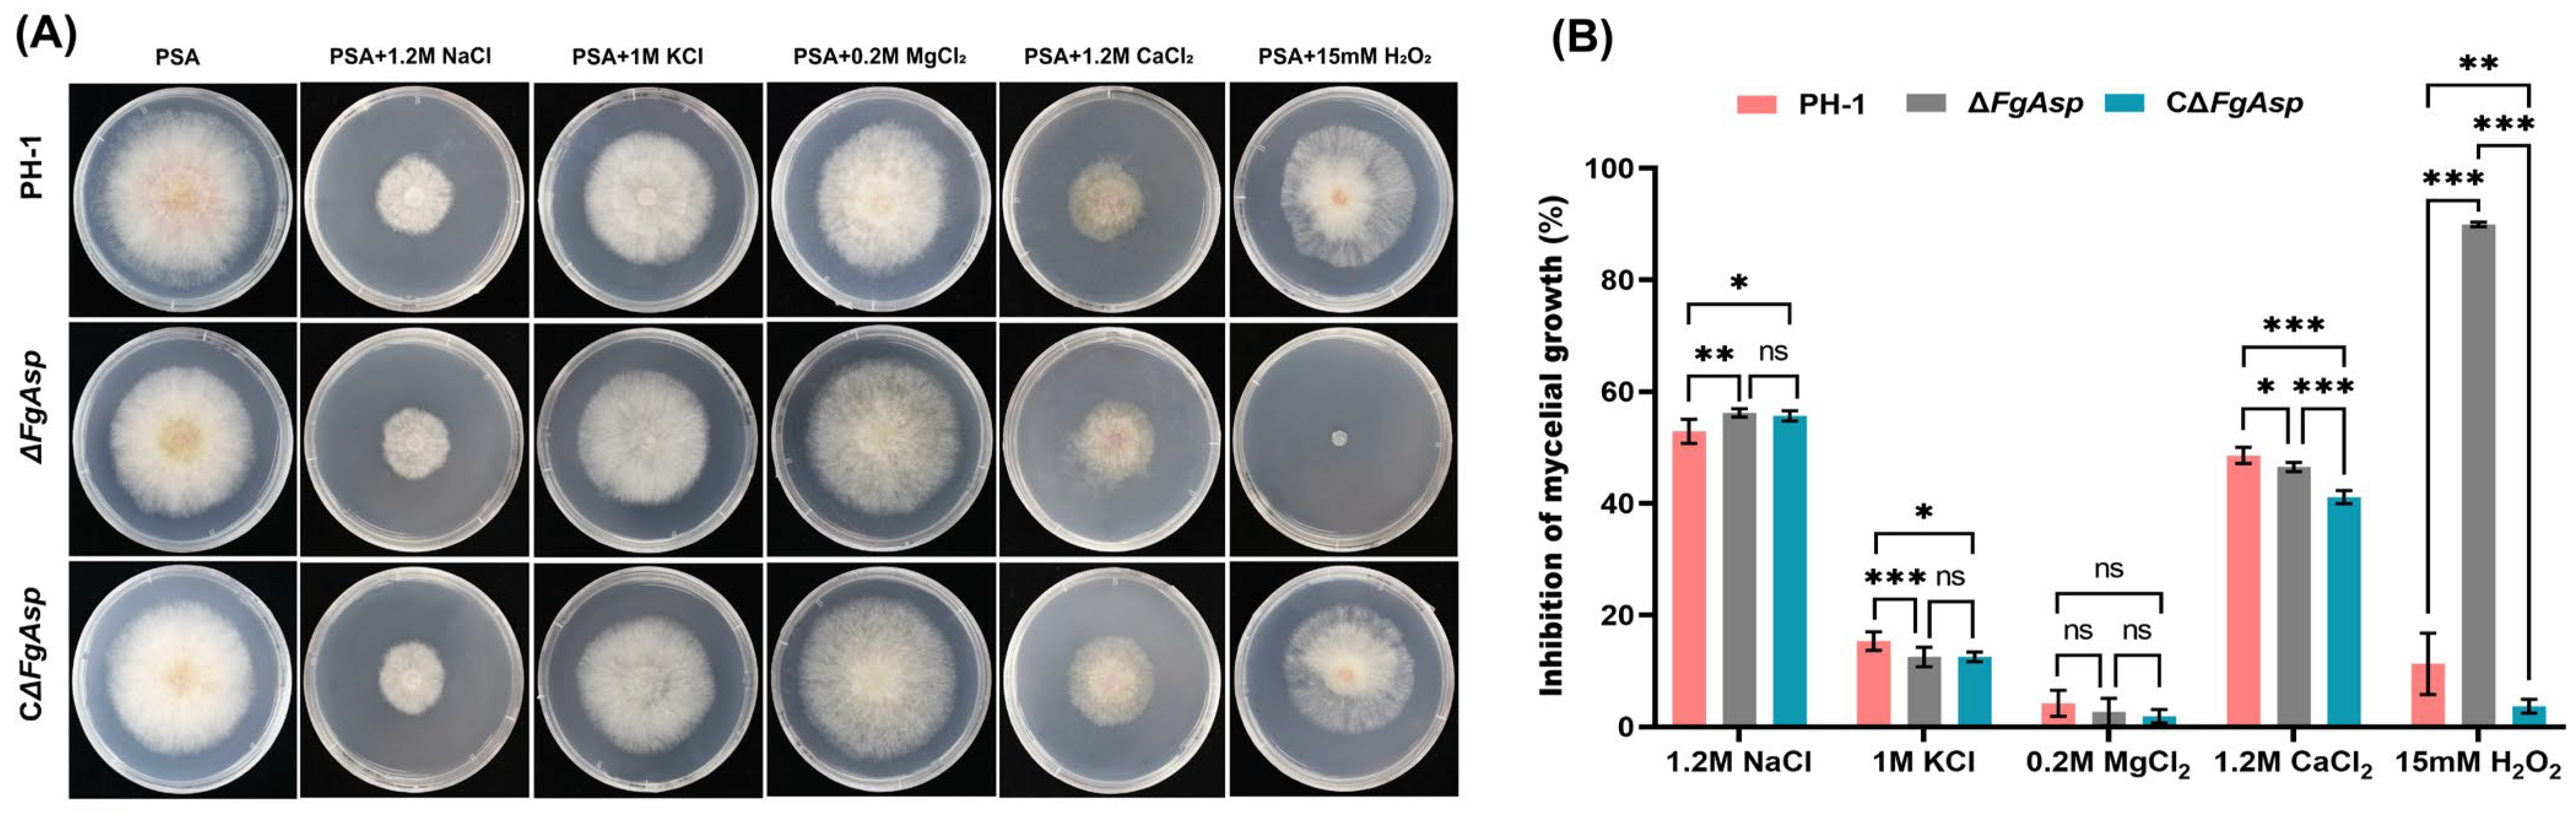
Jof 10 00879 g008

Functional Characterization of FgAsp, a Gene Coding an Aspartic Acid Protease in Fusarium graminearum
Abstract
1. Introduction
2. Materials and Methods
2.1. Screening for the Target Gene
2.2. Bioinformatics Analysis
2.3. Split PCR Construction of Gene Knockout Cassette
2.4. Gene Knockout and Complementation
2.5. Phenotypic Identification and Conidial Formation
2.6. Pathogenicity Tests
2.7. Sexual Reproduction Assays
2.8. Determining DON Content and TRI Genes Expression Analysis
2.9. Sensitivity to External Stress and Transport of Different Sugars
3. Results
3.1. Bioinformatics Analysis
3.2. Deletion of the Gene FgAsp Is of Significant Importance for Mycelial Growth of F. graminearum
3.3. FgAsp Gene Is Involved in the Production and Germination of Conidia
3.4. FgAsp Gene Is Crucial for Plant Infection
3.5. Deletion of the FgAsp Gene Leads to Reduction in the Sexual Reproductive Ability
3.6. Production of DON Is Positively Regulated by FgAsp
3.7. FgAsp Positively Regulates Tolerance to Hydrogen Peroxide
3.8. The FgAsp Gene Affects the Utilization of Arabinose
4. Discussion
Supplementary Materials
Author Contributions
Funding
Institutional Review Board Statement
Informed Consent Statement
Data Availability Statement
Acknowledgments
Conflicts of Interest
References
- O’Donnell, K.; Ward, T.J.; Geiser, D.M.; Corby Kistler, H.; Aoki, T. Genealogical concordance be-tween the mating type locus and seven other nuclear genes supports formal recognition of nine phylogenetically distinct species within the Fusarium graminearum clade. Fungal Genet. Biol. FG & B 2004, 41, 600–623. [Google Scholar]
- Qiu, J.; Xu, J.; Shi, J. Fusarium Toxins in Chinese Wheat since the 1980s. Toxins 2019, 11, 248. [Google Scholar] [CrossRef] [PubMed]
- Lee, H.J.; Ryu, D. Worldwide Occurrence of Mycotoxins in Cereals and Cereal-Derived Food Products: Public Health Perspectives of Their Co-occurrence. J. Agric. Food Chem. 2017, 65, 7034–7051. [Google Scholar] [CrossRef] [PubMed]
- Jiang, C.; Zhang, C.K.; Wu, C.L.; Sun, P.P.; Hou, R.; Liu, H.Q.; Wang, C.F.; Xu, J.R. TRI6 and TRI10 play different roles in the regulation of deoxynivalenol (DON) production by cAMP signalling in Fusarium graminearum. Environ. Microbiol. 2016, 18, 3689–3701. [Google Scholar] [CrossRef] [PubMed]
- Darwish, W.S.; Ikenaka, Y.; Nakayama, S.M.M.; Ishizuka, M. An Overview on Mycotoxin Contami-nation of Foods in Africa. J. Vet. Med. Sci. 2014, 76, 789–797. [Google Scholar] [CrossRef]
- Ma, L.-J.; Geiser, D.M.; Proctor, R.H.; Rooney, A.P.; O’Donnell, K.; Trail, F.; Gardiner, D.M.; Manners, J.M.; Kazan, K. Fusarium Pathogenomics. Annu. Rev. Microbiol. 2013, 67, 399–416. [Google Scholar] [CrossRef]
- Alexander, N.J.; Proctor, R.H.; McCormick, S.P. Genes, gene clusters, and biosynthesis of trichothecenes and fumonisins in Fusarium. Toxin Rev. 2009, 28, 198–215. [Google Scholar] [CrossRef]
- Dweba, C.C.; Figlan, S.; Shimelis, H.A.; Motaung, T.E.; Sydenham, S.; Mwadzingeni, L.; Tsilo, T.J. Fusarium head blight of wheat: Pathogenesis and control strategies. Crop Prot. 2017, 91, 114–122. [Google Scholar] [CrossRef]
- Starkey, D.E.; Ward, T.J.; Aoki, T.; Gale, L.R.; Kistler, H.C.; Geiser, D.M.; Suga, H.; Toth, B.; Varga, J.; O’Donnell, K. Global molecular surveillance reveals novel Fusarium head blight species and trichothecene toxin diversity. Fungal Genet. Biol. FG & B 2007, 44, 1191–1204. [Google Scholar]
- Alisaac, E.; Mahlein, A.-K. Fusarium Head Blight on Wheat: Biology, Modern Detection and Di-agnosis and Integrated Disease Management. Toxins 2023, 15, 192. [Google Scholar] [CrossRef]
- Faro, C.; Gal, S. Aspartic proteinase content of the Arabidopsis genome. Curr. Protein Pept. Sci. 2005, 6, 493–500. [Google Scholar] [CrossRef] [PubMed]
- Rawlings, N.D.; Barrett, A.J. Families of aspartic peptidases and families with unknown catalytic mechanisms. Enzym. Methods 1995, 248, 105–120. [Google Scholar]
- Hánová, I.; Brynda, J.; Houštecká, R.; Alam, N.; Sojka, D.; Kopáček, P.; Marešová, L.; Vondrášek, J.; Horn, M.; Schueler-Furman, O.; et al. Novel structural mechanism of allosteric regulation of aspartic peptidases via an evolutionarily conserved exosite. Cell Chem. Biol. 2018, 25, 318–329.e4. [Google Scholar] [CrossRef] [PubMed]
- Kulshrestha, A.; Gupta, P. Secreted aspartyl proteases family: A perspective review on the regulation of fungal pathogenesis. Future Microbiol. 2023, 18, 295–309. [Google Scholar] [CrossRef]
- Dou, K.; Wang, Z.; Zhang, R.; Wang, N.; Fan, H.; Diao, G.; Liu, Z. Cloning and characteristic analysis of a novel aspartic protease gene Asp55 from Trichoderma asperellum ACCC30536. Microbiol. Res. 2014, 169, 915–923. [Google Scholar] [CrossRef]
- Bras, G.; Satala, D.; Juszczak, M.; Kulig, K.; Wronowska, E.; Bednarek, A.; Zawrotniak, M.; Rapala-Kozik, M.; Karkowska-Kuleta, J. Secreted aspartic proteinases: Key factors in Candida infections and host-pathogen interactions. Int. J. Mol. Sci. 2024, 25, 4775. [Google Scholar] [CrossRef]
- Puri, S.; Kumar, R.; Chadha, S.; Tati, S.; Conti, H.R.; Hube, B.; Cullen, P.J.; Edgerton, M. Secreted Aspartic Protease Cleavage of Candida albicans Msb2 Activates Cek1 MAPK Signaling Affecting Biofilm Formation and Oropharyngeal Candidiasis. PLoS ONE 2012, 7, e46020. [Google Scholar] [CrossRef]
- Muthamil, S.; Prasath, K.G.; Priya, A.; Precilla, P.; Pandian, S.K. Global proteomic analysis deciphers the mechanism of action of plant derived oleic acid against Candida albicans virulence and biofilm formation. Sci. Rep. 2020, 10, 5113. [Google Scholar] [CrossRef]
- Kim, J.S.; Lee, K.T.; Bahn, Y.S. Secreted aspartyl protease 3 regulated by the Ras/cAMP/PKA pathway promotes the virulence of Candida auris. Front. Cell. Infect. Microbiol. 2023, 13, 1257897. [Google Scholar] [CrossRef]
- Deng, J.J.; Huang, W.Q.; Li, Z.W.; Lu, D.L.; Zhang, Y.; Luo, X.C. Biocontrol activity of recombinant aspartic protease from Trichoderma harzianum against pathogenic fungi. Enzym. Microb. Technol. 2018, 112, 35–42. [Google Scholar] [CrossRef]
- Wang, C.; Zheng, Y.; Liu, Z.; Qian, Y.; Li, Y.; Yang, L.; Liu, S.; Liang, W.; Li, J. The secreted FolAsp aspartic protease facilitates the virulence of Fusarium oxysporum f. sp. lycopersici. Front. Microbiol. 2023, 14, 1103418. [Google Scholar] [CrossRef] [PubMed]
- Bekalu, Z.E.; Dionisio, G.; Madsen, C.K.; Etzerodt, T.; Fomsgaard, I.S.; Brinch-Pedersen, H. Barley Nepenthesin-Like Aspartic Protease HvNEP-1 Degrades Fusarium Phytase, Impairs Toxin Production, and Suppresses the Fungal Growth. Front. Plant Sci. 2021, 12, 702557. [Google Scholar] [CrossRef] [PubMed]
- Darino, M.; Jaiswal, N.; Darma, R.; Kroll, E.; Urban, M.; Xiang, Y.; Kim, H.S.; Myers, A.; Scofield, S.; Innes, R.W.; et al. The Fusarium graminearum effector protease FgTPP1 suppresses immune responses and facilitates Fusarium Head Blight Disease. bioRxiv 2024, 2024, 610543. [Google Scholar] [CrossRef]
- Finn, R.D.; Coggill, P.; Eberhardt, R.Y.; Eddy, S.R.; Mistry, J.; Mitchell, A.L.; Potter, S.C.; Punta, M.; Qureshi, M.; Sangrador-Vegas, A.; et al. The Pfam protein families database: Towards a more sustainable future. Nucleic Acids Res. 2016, 44, D279–D285. [Google Scholar] [CrossRef]
- Schwede, T.; Kopp, J.; Guex, N.; Peitsch, M.C. SWISS-MODEL: An automated protein homology-modeling server. Nucleic Acids Res. 2003, 31, 3381–3385. [Google Scholar] [CrossRef]
- Pollenz, R.S.; Bland, J.; Pope, W.H. Bioinformatic characterization of endolysins and holin-like membrane proteins in the lysis cassette of phages that infect Gordonia rubripertincta. PLoS ONE 2022, 17, e0276603. [Google Scholar] [CrossRef]
- Lu, P.; Chen, D.; Qi, Z.; Wang, H.; Chen, Y.; Wang, Q.; Jiang, C.; Xu, J.-R.; Liu, H. Landscape and regulation of alternative splicing and alternative polyadenylation in a plant pathogenic fungus. J. New Phytologist. 2022, 235, 674–689. [Google Scholar] [CrossRef]
- Petersen, T.N.; Brunak, S.; von Heijne, G.; Nielsen, H. SignalP 4.0: Discriminating signal peptides from transmembrane regions. Nat. Methods 2011, 8, 785–786. [Google Scholar] [CrossRef]
- Bryksin, A.; Matsumura, I. Overlap extension PCR cloning. Methods Mol. Biol. 2013, 1073, 31–42. [Google Scholar]
- Wang, H.; Zhang, T.; Liu, J. Development of a PEG-mediated transformation system for efficient gene disruption in Fusarium species. J. Microbiol. 2018, 56, 129–136. [Google Scholar]
- Menke, J.; Weber, J.; Broz, K.; Kistler, H.C. Cellular development associated with induced mycotoxin synthesis in the filamentous fungus Fusarium graminearum. PLoS ONE 2013, 8, e63077. [Google Scholar] [CrossRef] [PubMed]
- Cao, Y.; Liu, Y. Quantitative analysis of wheat genes related to protein content by qPCR. J. Plant Biol. 2019, 62, 51–58. [Google Scholar]
- Cao, Y.; Liu, Y. Determination of deoxynivalenol (DON) and its derivatives: Current status of analytical methods. Food Chem. 2022, 350, 129–135. [Google Scholar]
- Dong, G.; Liu, Y.; Wu, Y.; Tu, J.; Chen, S.; Liu, N.; Sheng, C. Novel non-peptidic small molecule inhibitors of secreted aspartic protease 2 (SAP2) for the treatment of resistant fungal infections. Chem. Commun. 2018, 54, 13535–13538. [Google Scholar] [CrossRef]
- Mukherjee, S.; Bhakta, K.; Ghosh, A.; Ghosh, A. Ger1 is a secreted aspartic acid protease essential for spore germination in Ustilago maydis. Yeast 2023, 40, 102–116. [Google Scholar] [CrossRef]
- Suárez, M.B.; Sanz, L.; Chamorro, M.I.; Rey, M.; González, F.J.; Llobell, A.; Monte, E. Proteomic analysis of secreted proteins from Trichoderma harzianum: Identification of a fungal cell wall-induced aspartic protease. Fungal Genet. Biol. 2005, 42, 924–934. [Google Scholar] [CrossRef]
- Wang, Y.; Xue, W.; Sims, A.H.; Zhao, C.; Wang, A.; Tang, G.; Qin, J.; Wang, H. Isolation of four pepsin-like protease genes from Aspergillus niger and analysis of the effect of disruptions on heterologous laccase expression. Fungal Genet. Biol. 2008, 45, 17–27. [Google Scholar] [CrossRef]
- Hube, B.; Sanglard, D.; Odds, F.C.; Hess, D.; Monod, M.; Schäfer, W.; Brown, A.J.; Gow, N.A. Disruption of each of the secreted aspartyl proteinase genes SAP1, SAP2, and SAP3 of Candida albicans attenuates virulence. Infect. Immun. 1997, 65, 3529–3538. [Google Scholar] [CrossRef]
- Smolenski, G.; Sullivan, P.A.; Cutfield, S.M.; Cutfield, J.F. Analysis of aspartic proteases secreted by Candida albicans: Purification and characterisation of individual Sap1, Sap2 and Sap3 isozymes. Microbiology 1997, 143, 349–356. [Google Scholar] [CrossRef][Green Version]
- Kadry, A.A.; El-Ganiny, A.M.; El-Baz, A.M. Relationship between Sap prevalence and biofilm formation among resistant clinical isolates of Candida albicans. Afr. Health Sci. 2018, 18, 1166–1174. [Google Scholar] [CrossRef]
- Ernst, J.F. Transcription factors in Candida albicans– environmental control of morphogenesis. Microbiology 2000, 146, 1763–1774. [Google Scholar] [CrossRef] [PubMed]
- Felk, A.; Kretschmar, M.; Albrecht, A.; Schaller, M.; Beinhauer, S.; Nichterlein, T.; Sanglard, D.; Korting, H.C.; Schäfer, W.; Hube, B. Candida albicans hyphal formation and the expression of the Efg1-regulated proteinases Sap4 to Sap6 are required for the invasion of parenchymal organs. Infect. Immun. 2002, 70, 3689–3700. [Google Scholar] [CrossRef] [PubMed]
- Korting, H.; Hube, B.; Oberbauer, S.; Januschke, E.; Hamm, G.; Albrecht, A.; Borelli, C.; Schaller, M. Reduced expression of the hyphal-independent Candida albicans proteinase genes SAP1 and SAP3 in the efg1 mutant is associated with attenuated virulence during infection of oral epithelium. J. Med. Microbiol. 2003, 52, 623–632. [Google Scholar] [CrossRef] [PubMed]
- Adnan, M.; Zheng, W.; Islam, W.; Arif, M.; Abubakar, Y.S.; Wang, Z.; Lu, G. Carbon catabolite repression in filamentous fungi. Int. J. Mol. Sci. 2017, 19, 48. [Google Scholar] [CrossRef] [PubMed]
- Huang, J.; Zhao, X.; Cheng, K.; Jiang, Y.; Ouyang, Y.; Xu, C.; Li, X.; Xiao, J.; Zhang, Q. OsAP65, a rice aspartic protease, is essential for male fertility and plays a role in pollen germination and pollen tube growth. J. Exp. Bot. 2013, 64, 3351–3360. [Google Scholar] [CrossRef]
- Pissarra, J.; Pereira, C.; Costa, D.; Figueiredo, A.; Macedo, P.; Teixeira, J.; Pereira, M.S. From Flower to Seed Germination in Cynara cardunculus: A Role for Aspartic Proteinases. 2007. Available online: https://repositorio-aberto.up.pt/handle/10216/82523 (accessed on 7 December 2024).

Disclaimer/Publisher’s Note: The statements, opinions and data contained in all publications are solely those of the individual author(s) and contributor(s) and not of MDPI and/or the editor(s). MDPI and/or the editor(s) disclaim responsibility for any injury to people or property resulting from any ideas, methods, instructions or products referred to in the content. |
© 2024 by the authors. Licensee MDPI, Basel, Switzerland. This article is an open access article distributed under the terms and conditions of the Creative Commons Attribution (CC BY) license (https://creativecommons.org/licenses/by/4.0/).
Share and Cite
Li, P.; Fu, Z.; Wang, M.; Yang, T.; Li, Y.; Ma, D. Functional Characterization of FgAsp, a Gene Coding an Aspartic Acid Protease in Fusarium graminearum. J. Fungi 2024, 10, 879. https://doi.org/10.3390/jof10120879
Li P, Fu Z, Wang M, Yang T, Li Y, Ma D. Functional Characterization of FgAsp, a Gene Coding an Aspartic Acid Protease in Fusarium graminearum. Journal of Fungi. 2024; 10(12):879. https://doi.org/10.3390/jof10120879
Chicago/Turabian StyleLi, Ping, Zhizhen Fu, Mengru Wang, Tian Yang, Yan Li, and Dongfang Ma. 2024. "Functional Characterization of FgAsp, a Gene Coding an Aspartic Acid Protease in Fusarium graminearum" Journal of Fungi 10, no. 12: 879. https://doi.org/10.3390/jof10120879
APA StyleLi, P., Fu, Z., Wang, M., Yang, T., Li, Y., & Ma, D. (2024). Functional Characterization of FgAsp, a Gene Coding an Aspartic Acid Protease in Fusarium graminearum. Journal of Fungi, 10(12), 879. https://doi.org/10.3390/jof10120879

